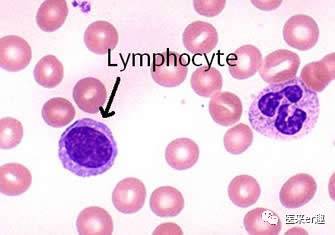
儿童发烧血常规解读,儿童感冒发烧的基本常识

前言:血常规是最常见的检验项目之一,基本上孩子们一发热就会被要求检查一个血常规,医生根据血常规评断孩子是病情,并以此给与药物。宝妈们虽然拿到血常规后一头雾水,但也一直觉得这种做法天经地义。但是这样检查对吗?血常规里面的内容又是什么意思呢?能根据血常规判别细菌病毒感染吗?今天咱们就来理一理。
注意啦,咱们今天讲的只是儿童的血常规的解读哦。先讲最常见的,孩子发烧感冒时的血常规怎么看。大家掌握后,后面还有拔高题目哦。
好啦,下面开始了。
1、血常规里都有什么?都有什么意义?
看似血常规里项目很多,其实归纳一下,就3大类,就是白细胞类,红细胞类,血小板,大家把这3类弄清楚就行了,这样一下就简单多了。
下图红框里面(1-11)是白细胞类的参数,蓝色框内的(12-20)是红细胞类的参数,绿色框内(21-24)是血小板类的。
有些血常规里面会带着检查C反应蛋白,也给大家普及下。
对于孩子出现感冒、发烧症状的,对于家长朋友们,咱们弄懂了白细胞和C反应蛋白就够了。
白细胞相关的参数及意义
白细胞就是人体的*队军**,起着消灭敌人,也就是消灭细菌、病毒等病原的作用。当然,就像解放军叔叔在灾难出现时也会当挺身而出一样,白细胞在过敏等情况的时候,也会发挥重要作用。简单一句话,只要身体受到损害,白细胞就会冲到一线。

为了满足多方面的要求,白细胞分成了好几种,中性粒细胞、淋巴细胞、单核细胞、嗜酸性粒细胞、嗜碱性粒细胞全部加起来,组成白细胞。这里面,淋巴+粒细胞占了90%以上,是最主要的,另外细胞加起来不到10%。感冒发烧时,家长们只要了解了中性粒细胞、淋巴细胞就足够了。
中性粒细胞有吞噬细菌的作用,平时在血管里面巡逻。如果出现局部细菌感染,他们很快的就从血管运输到感染部位,吞噬并杀灭细菌。细菌感染不是一下子就能压下去的,身体会快速的、不断的产生中性粒细胞去杀菌。所以,细菌感染的时候,通常是中性粒细胞升高,相应的,白细胞也就升高了。

上图就是漂亮的白细胞,给他点个赞!
病毒比细菌小多了,中性粒细胞吞噬不了它们,这时就得靠淋巴细胞了。淋巴细胞能识别出病毒,并产生相应的抗体,这些抗体和病毒结合后,病毒就不能搞破坏了。同时,淋巴细胞还能检测出被病毒感染的细胞,并把这个信息上报,然后身体就会把这些细胞给杀掉,防止病毒在细胞内大量繁殖。
所以,在病毒感染的时候,淋巴细胞会轻度升高。并且这个时候,病毒会抑制骨髓生成粒细胞的作用,所以,中性粒细胞是大大减少的,以上结果综合后,是白细胞降低。
上面箭头处,就是抗击病毒的淋巴细胞。
以上白细胞的变化,在大多数情况下都是正确的,所以在感冒发烧时,如果已经查了血常规,家长们可以通过白细胞总数、淋巴细胞、中性粒细胞分下孩子的感染情况。
大家可能看到这,觉得头又大了,这些细胞的数值好烦啊,根本记不住啊。哈哈,您放心好了,根本不用记忆啊,血常规后面都有参考值的,直接看就行。并且这11项里面,咱们只看3项目就够了:白细胞总数,淋巴细胞百分比,中性粒细胞百分比,别的具体细胞数量有多少,不用管。
通过白细胞总数判断到底是升高了还是降低了,升高提示细菌感染的可能性大; 通过淋巴细胞百分比,中性粒细胞百分比这两项,粗略的分析是病毒还是细菌感染,淋巴升高,病毒感染可能性大,中性粒细胞升高细菌感染可能性大。
好多医院血常规后面的参考值都是大人的,对于儿童是不适合的,下面咱们把儿童的参考值附上。
白细胞总数:新生儿(15.0~20.0)×10^9/L,6个月至2岁(11.0~12.0)×10^9/L,儿童(5.0~12.0 )×10^9/L。
中性粒细胞百分比:出生时60-70%,4-6天50%,到4-6岁前30-50%,大于6岁50-70%。
淋巴细胞百分比:出生时30-40%,4-6天50%,到4-6岁前40-60%,大于6岁30-40%。
从上面可以看到,在生后中性粒细胞百分比高;在生后4-6天,中性粒细胞和淋巴细胞差不多,之后淋巴细胞升高,占优势;到4-6岁时,二者比例差不多;之后粒细胞占优势。

刚才我们也说了,通过以上情况判断,在大多数情况下是可以的,对于家长们分析孩子的感冒发烧时足够了;但是有些感染时,淋巴细胞和中性粒细胞的改变和上面说的不相符,如果家长们还有钻研精神,请看下面的孩子感冒发烧时,医生怎么评估血常规?。
2、C 反应蛋白是什么?能提示感染吗?
好多血常规检查里面,会带着把C反应蛋白也检查了。下面咱们说说C反应蛋白,英文简称是CRP,是一种在炎症、应激时,急剧上升的蛋白,这种蛋白是肝细胞合成的,能帮助识别和清除病原体,有抗炎效果。
细菌感染的时候,CRP升高较为明显;病毒感染的时候,CRP升高的低或者不升高,这条对于大部分儿童感冒发烧时的病原,都是适用的。所以家长们可以通过这条,也能粗略的分析下孩子是病毒还是细菌感染,如果是病毒感染,就可以放心的不用使用抗生素了。
同样,还有部分病原感染时,CRP的反应不是上面说的那么典型,如果家长们还想钻研下,请看下面的孩子感冒发烧时,医生怎么评估血常规?
3、感冒发烧用检查血常规吗?多久检查血常规?
一般而言,儿童的感冒发热多是病毒性的,根据孩子的表现,比如发热会反复,但是不会越来越严重;孩子不发热的时候,状态很好;流鼻涕、咳嗽等症状会加重,但是发热会减轻等,可以比较清楚的判断是病毒感染,这时就不用查血常规了。
如果孩子情况不是上面说的,孩子症状较重,或者孩子特别小,3月龄以下,那建议还是查个血常规,如果提示细菌感染,那该用药就用药,别耽误了孩子。
4、如果要进行血常规检查,那什么时间查比较好呢?
一般来说,在感冒、发热的12小时内检验血常规的意义不大,因为这时体内的白细胞、C反应蛋白等刚反应没过久,还处于继续的反应中,没有稳定下来,这时查,会有误导作用。比如,病毒感染刚开始的时候,中性粒细胞还没有下降,有时甚至因为炎症问题,还有升高的表现,白细胞数量还是很高,这时如果查了血,那可能误以为是细菌感染了。
如果孩子发热、感冒症状3天还没有好转的趋势,甚至加重了,那这时可以检查个血常规。这时血常规已经稳定了,有指导意义。当然,鉴于咱们家长一见宝宝生病,着急的根本等不到3天,那也至少等24小时再去查血哦,不然真的没有意义,孩子还被扎一针。
5、孩子感冒发烧时,医生怎么评估血常规?
孩子出现感冒发烧了,血常规也是24小时之后检查的,这时医生认为这份血常规是有意义的,可以进行分析,但是分析时,会和孩子的临床表现相结合,不会只看血常规结果的。这是因为上面咱们说的,白细胞、中性粒细胞、淋巴细胞的改变,不都是那么规律的,大家可以看下面的例子。
如果孩子精神状态非常差,不吃不喝不玩,发热总是不退,这时,即使白细胞非常低、中性粒细胞非常低,也不能认为是病毒感染。因为严重的细菌感染的时候,中性粒细胞都去杀细菌去了,和细菌同归于尽了,新的白细胞还没有生产出来,那可不就低吗。
如果孩子发热有反复,但精神还行,就是有些烦躁,一查血常规,白细胞升的老高了,CRP也升高,感觉是细菌感染了对吧?但是这是EB病毒感染,这时的白细胞升高是淋巴细胞大量增生导致的;CRP升高明显是因为孩子的炎症反应较重,导致的,还记得咱们上面讲的,炎症期,CRP会升高吧?这里CRP升高就是因为病毒导致炎症的原因。
所以,通过上面讲的,分析血常规时,一定要结合孩子的病情,单看血常规是不行的。另外,如果通过血常规+孩子表现也不能分析出来时,医生还会开具其他检查,比如检查怀疑的病原,进行PCT(降钙素原),ESR(血沉),血培养等检查,明确病因。
好了,上面讲了最常用的,感冒发烧时血常规的分析,下面该讲讲血常规里面的红细胞和血小板啦。
6、血常规里面的红细胞和血小板
(1)红细胞相关的参数及意义
红细胞是人体内的“运输队”。它把氧气运送到全身各处,把回收的二氧化碳送到肺部排出体外。
关于红细胞相关参数,咱们能知道怎么判断贫血,以及是不是缺铁性贫血就行了。所以,咱们要了解有:血红蛋白浓度(Hb),平均红细胞体积(MCV),平均红细胞血红蛋白含量(MCH),平均红细胞血红蛋白浓度(MCHC)。
看着很多,其实大家记住,第一项(Hb)降低说明贫血,后三项低,提示缺铁性贫血就够了。呵呵,这样就简单了吧?
对于是否贫血,大家可以参考下面的数值:血红蛋白在新生儿期<145 g/L,1~4 月时<90 g/L,4~6 个月时<100 g/L,6 个月~6 岁时<110 g/L,6~14 岁时<120 g/L时可以诊断贫血。
血红蛋白的合成需要铁,如果长期缺乏铁,那么血红蛋白合成就少,而血红蛋白是红细胞的重要组成部分,所以红细胞就小,颜色也不怎么红,这就是缺铁导致的小细胞、低色素性贫血。后面3项就是提示红细胞体积以及血红蛋白的,所以可以提示是否缺铁。具体数值根据血常规上的参考值就可以啦。
另外给大家拔高以下,在细菌感染的时候,会抑制骨髓制造红细胞,导致暂时性的贫血,等疾病好了孩子贫血就会自行恢复了,不用做什么处理的。
(2)血小板相关参数及意义
血小板相关参数里面,就知道血小板数量就行了。血小板是血管内的修补匠,当血管有破口,血小板负责把破口封堵上,避免大量出血。如果血小板数目降低,那么血管破口后,血就止不住。另外,血小板对维持血管完整性也有很重要的作用,血小板少的时候,血管可能会出现多处漏洞,血会渗出血管,导致皮肤上有好多出血点。
如果发现孩子身上起了出血点后,特别是前一段时间有过病毒感染,或者注射过疫苗的,建议去医院检查个血常规,看血小板数目,如果小于100×10^9/L,提示血小板减少,那就需要医生评估下一步的诊疗方案了。
血小板少了不行,多了也不行。大量的血小板可能在血管内没有破口的地方聚集,互相黏在一起形成血栓,如果血栓随着血流流入心脏、大脑,那是非常危险的。所以,血小板增高时,总是在400—600×10^9/L的,尤其是之前还有过感染性疾病的,要请医生评估下是继续观察,还是需要服用抗血小板凝集药物。
(3)最后,讲一个大家都挺感兴趣的话题。 嗜酸性粒细胞升高就是过敏吗?
从上面咱们知道嗜酸性粒细胞也是白细胞的一种,但是嗜酸性粒细胞吞噬细菌的作用非常弱,所以基本起不到抗感染作用。他的作用是限制体内的过敏反应。
比如你过敏后,起了个大包,非常痒,如果不是有嗜酸性粒细胞,可能这个包会更大,更痒,让你更难受。这种细胞就是能让你好过些。
所以,在过敏性疾病时,嗜酸性粒细胞会升高。但是,大家要注意的是,虽然过敏是嗜酸性粒细胞升高最常见的原因,但不是说嗜酸性粒细胞升高就能明确是过敏性疾病,别的比如寄生虫感染、风湿、血液系统疾病时,他也会升高哦。
所以不能以为嗜酸性粒细胞升高就是过敏了,就给孩子忌口,不吃这不吃那的治疗。还是要结合孩子的表现判断哦。
作者: 儿科医生孔令凯 医来er趣科普作者
声明:原创作品,首发医来er趣公众号(ID:yilaierqu2016),欢迎来公众号与医生交流女性健康、备孕和科学育儿,图片源自网络,如有不当请联系我们,禁止私自转载,转载请联系我们。
医来er趣,长期邀请三甲医院妇产科、儿科、疫苗、皮肤科、营养科和心理方面的医生为您做免费的科普课堂和在线答疑。旨在让女人更健康,怀孕更容易,育儿更加科学有趣。